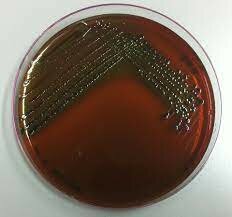
Eagle

-
Logró mantener vivos por más de un mes hematíes de anfibios.
-
Demostró la factibilidad de mantener células vivas en medios artificiales.
-
Crecimiento de fibra nerviosa del embrión de la rana in vitro.
-
 Utilizó plasma de pollo para nutrir los explantes de tejidos embrionarios de pollo,
Utilizó plasma de pollo para nutrir los explantes de tejidos embrionarios de pollo,
fue uno de los primeros medios que permitió la observación y el crecimiento de tejidos. -
Demostró la posibilidad de mantener en cultivo células de embrión de pollo, en condiciones de asepsia, durante un tiempo superior a la vida del animal.
-
Utilizaron por primera vez extractos enriquecidos en tripsina para disociar células de los tejidos. (Fotografía: Rous)
-
Subcultivo de líneas celulares fibroblásticas.
-
 Diferenciación de los tejidos embrionarios en cultivo de órganos (1925-1926).
Diferenciación de los tejidos embrionarios en cultivo de órganos (1925-1926). -
Cultivo de órganos de huesos largos del pollo.
-
Aislaron células de línea celular L de ratón y mostraron que eran capaces de formar clones en el cultivo de tejidos.
-
Clonación de células L.
-
Introducción del uso de antibióticos en el cultivo de tejidos.
-
El virus de la poliomielitis puede propagarse en cultivos celulares de origen diferente al tejido nervioso.
-
Establecen la primera línea celular continua HeLa y el medio usado fue complejo y poco definido: plasma de pollo, extracto de embrión bovino y suero de cordón umbilical humano.
-
Mostraron que el factor de crecimiento nervioso estimula el
crecimiento de los axones en tejidos en cultivo. -
Realiza la primera investigación sistemática de los requerimientos nutritivos de las células en cultivo.
-
Usaron por primera vez en un medio de cultivo antibióticos para prevenir la contaminación de los cultivos de fibroblastos. Pudieron mantener estos cultivos durante unos 12 pases, pero no consiguieron establecer líneas estables.
-
Fusión celular - Hibridación celular somática.
-
Pluripotencia de las células madre embrionarias.
-
Introduce el primer medio definido libre de suero capaz de mantener algunas células de mamífero en cultivo indefinidamente
-
Heterocariontes, híbridos hombre-ratón.
-
 Establecen la primera línea celular estable de neuroblastoma.
Establecen la primera línea celular estable de neuroblastoma. -
Hacen posible la mirada a las estructuras subcelulares y organelas de una célula con primeras fotos de una célula por medio de microscopio electrónico.
-
Establecen la primera línea celular hibrida productora de anticuerpos
monoclonales. El establecimiento de la tecnología de obtención de anticuerpos monoclonales les valió el Premio Nóbel. -
Publican una serie de trabajos que demuestran las distintas necesidades de hormonas y factores de crecimiento que precisan diferentes líneas celulares.
-
Aíslan y cultivan células madre embrionarias pluripotenciales del ratón
-
Cultivo a escala industrial de células transfectadas para la producción de biofármacos.
-
Cultivo de células madre embrionarias humanas.
-
Proyecto Genoma Humano.
-
Explotación de la ingeniería tisular.
-
Realizaron un estudio en cultivos celulares de un
insecto vector del parásito Leishmania, en busca del abordaje in
vitro de estudios de enfermedades transmitidas por vectores. -
Reprogramación de células adultas para que se conviertan en células madre pluripotentes (iPS).
-
Inducción de células iPS mediante reprogramación con ácido valproico.
-
Investigaciones realizadas sobre células vero modificadas genéticamente, las presentan como una alternativa
para mejorar la producción de vacunas contra el polio y el rotavirus.
Plan projects on a visual timeline
Map milestones, phases, deadlines, and key events in one place so the sequence is easier to see and share. Timetoast is a timeline maker for work, school, research, and stories.